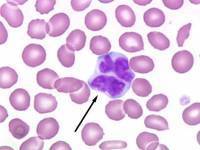
Неходжкинская лимфома

Медицинский туризм становится все более популярным. Миллионы людей ежегодно отправляются в страны с высоким уровнем развития медицины для того, чтобы восстановить свое здоровье. Информация о достижениях медиков, статистика успешных операций и методик консервативного лечения тяжелых заболеваний, быстрота оказания медицинских услуг сделали Израиль столицей мирового туризма. А доступность медицинских услуг в Израиле – их стоимость на 30-40% меньше, чем в европейских странах – способствуют ежегодному увеличению потока пациентов.
Онкология – область медицины, в которой израильские медики стали лидерами. Имена врачей клиники Ихилов давно стали всемирно известными, благодаря их новаторским разработкам в области лечения неизлечимых раннее видов рака. Научно-исследовательская база Ихилов позволяет врачам разрабатывать инновационные методики лечения, основываясь на уникальном опыте лечения безнадежных случаев и достижениях современной науки и техники. Профессора клиники имеют успешный опыт лечения любых видов и стадий рака, в том числе и неходжкинской лимфомы. В последние годы неходжкинские лимфомы врачи Ихилов излечивают полностью.
Обратившись в клинику Ихилов, вам не придется ждать месяцами, когда подойдет ваша очередь. Система предоставления медицинских услуг в Ихилов построена таким образом, что вы сможете начать борьбу с болезнью сразу же, после заполнения анкеты на сайте клиники. В Ихилов вас не оставят один на один с недугом: организационные вопросы решает персональный консультант больницы. А профессора консультируют и контролируют состояние здоровья своих пациентов даже после возвращения на родину.
Лечение и диагностика неходжкинской лимфомы в Израиле – оптимальное решение для тех, кто настроен на победу. Лучшее в Израиле высокотехнологическое медицинское оборудование клиники Ихилов, врачи-новаторы в лечении онкозаболеваний, новейшие эффективные медицинские препараты для лечения рака – все это доступно пациентам клиники. Израильские врачи не отступают даже, если в родной стране пациента посчитали безнадежным. Мастерство и возможности профессоров Ихилов обросли легендами: они умеют побеждать рак. Диагностика опухоли по новейшим молекулярно-генетическим тестам и подбор индивидуальной схемы лечения, включающей все мировые достижения в сфере онкологии, дают высокие шансы на выздоровление при любых формах рака.
Как борются с раком в Ихилов
Персонализированная медицина Израиля подходит к лечению неходжкинской лимфомы, как и любого вида рака, индивидуально. Это значит, что израильские врачи не лечат онкологические заболевания одинаково, как это делают в большинстве стран мира. Устойчивое мнение в израильской медицине, что каждая опухоль индивидуальна, диктует и нестандартный подход к лечению неходжкинской лимфомы. Индивидуально, с учетом сопутствующих заболеваний, возраста и пола, разрабатывается схема лечения рака даже по стандартным методам и протоколам. Постоянно наблюдение лечащего врача и контрольные промежуточные диагностические исследования, позволяют быстро отреагировать изменением методики лечения в случае невосприимчивости применяемой терапии. В Ихилов отдают предпочтение консервативным методам лечения и органосохраняющим операциям. Поэтому лечение неходжкинской лимфомы в Израиле будет современным и оптимальным.
Персонализированная медицина Израиля подходит к лечению неходжкинской лимфомы, как и любого вида рака, индивидуально. Это значит, что израильские врачи не лечат онкологические заболевания одинаково, как это делают в большинстве стран мира. Устойчивое мнение в израильской медицине, что каждая опухоль индивидуальна, диктует и нестандартный подход к лечению неходжкинской лимфомы. Индивидуально, с учетом сопутствующих заболеваний, возраста и пола, разрабатывается схема лечения рака даже по стандартным методам и протоколам. Постоянно наблюдение лечащего врача и контрольные промежуточные диагностические исследования, позволяют быстро отреагировать изменением методики лечения в случае невосприимчивости применяемой терапии. В Ихилов отдают предпочтение консервативным методам лечения и органосохраняющим операциям. Поэтому лечение неходжкинской лимфомы в Израиле будет современным и оптимальным.
Химиотерапия
В Ихилов страх перед химиотерапией совершенно не оправдан. Профессора используют традиционные медицинские препараты, которые прекрасно себя зарекомендовали за годы терапии и не наносят вред организму. Инновационные лекарства, которые используют для лечения неходжкинской лимфомы, не оказывают побочных эффектов, которые требуют прекращения терапии. Любая схема медикаментозного лечения разрабатывается с учетом максимальной переносимости и минимальных побочных эффектов. Кроме того, израильские медики применяют при лечении неходжкинской лимфомы только оригинальные сертифицированные лекарственные средства известных мировых производителей. Исключение из терапии дженериков и подделок также обеспечивает надежный результат и снижение побочных эффектов.
При подборе препаратов для химиотерапии врачи Ихилов с помощью быстрой и точной диагностики устанавливают разновидность неходжкинской лимфомы, степень ее распространенности, уникальные особенности аномальных клеток. Сейчас неходжкинские лимфомы устанавливают по такой классификации: все лимфомы разделяют на две группы – лимфомы Ходжкина (лимфогранулематоз) и неходжкинские лимфомы, которых на сегодняшний день известно около 40 видов. Чаще всего встречается диффузная В-крупноклеточная лимфома, эта разновидность поражает более 30% пациентов. В основном неходжкинская лимфома развивается в возрасте 55-60 лет. Однако диагностируется неходжкинская лимфома у детей, у молодых людей в возрасте 22-30 лет. Одной из самых агрессивных разновидностей является диффузная неходжкинская лимфома. Лечение неходжкинской лимфомы в Израиле всегда планируется с учетом типа опухоли и возраста пациента.
Иммунотерапия
Иммунотерапия – новый эффективный метод лечения рака любого типа на всех стадиях. Борьба ученых за жизнь пациентов, страдающих неизлечимыми формами онкологических заболеваний принесла результаты – создание нового иммунологического метода и инновационных препаратов для его использования. Недавно в США успешно закончились клинические испытания иммунологического метода лечения диффузной неходжкинской лимфомы. Разработчик инновационного способа лечения рака – профессор Ихилов Зелиг Ашхар.
Иммунотерапия восстанавливает иммунную систему пациента, активизируя ее для самостоятельной борьбы с раком. Препараты, которые разрабатываются в рамках иммунотерапевтического метода возвращают иммунной системе способность различать и уничтожать аномальные клетки. В Ихилов для лечения неходжкинской лимфомы чаще используют группу иммунотерапевтических препаратов –моноклональные антитела. Эти препараты создаются с использованием достижений молекулярной биологии: ученые научились "обучать" клетки пациента искать и уничтожать опухолевые клетки, ориентируясь на взаимодействие специфических рецепторов на поверхности клеток.
Иммунотерапевтический метод применяется как в комплексной терапии, существенно повышая ее эффективность, так и в монотерапии. Это инновационное направление постоянно развивается, ученые всего мира проводят исследования для поиска новых эффективных препаратов для победы над болезнью ХХI века.
Лучевая терапия
Самое современное оборудование в Ихилов позволяет проводить лучевую терапию с положительным результатом. Лучевую терапию в клинике проводят с помощью суперсовременных медицинских установокTrueBeam, Novalis концентрируют луч строго на зоне поражения, которая определяется точными компьютерными расчетами. При этом облучению подвергают только аномальные клетки. Поскольку здоровые ткани и органы не повреждаются, облучение в случае необходимости проводят многократно под разными углами. Для полного разрушения раковых клеток лучевую терапию совмещают с химиотерапией и иммунотерапией. Инновационное медицинское оборудование обеспечивает положительный результат лечения, инновационные методы и новейшие препараты способствуют предотвращению рецидивов.
Трансплантация
Врачи Ихилов обладают беспрецедентным опытом проведения успешных хирургических вмешательств из-за большого количества пациентов с тяжелыми формами рака, которые прошли курс лечения в Израиле. Хирурги Ихилов виртуозно владеют техниками проведения операций на высокотехнологическом оборудовании, которое присутствует в немногих клиниках мира.
Диагностика: увидеть лицо врага
Диагностика в Израиле находится на самом высоком уровне в мире. Современное диагностическое оборудование обеспечивает точность и достоверность результатов исследований. При этом диагностика проводится быстро – всего 1-2 дня. Если результаты обследования, привезенные пациентом, лечащий врач в Ихилов сочтет достаточными и достоверными, диагностика в Израиле уже не нужна. Однако более трети диагнозов, поставленных в других странах, в Израиле не подтверждаются.
День первый:
Первичный осмотр и консультацию профессор-онколог проводит в день прибытия пациента в Израиль.
При необходимости профессор направляет пациента для сдачи необходимых анализов, прохождения диагностических процедур на следующий день. Первоначальный диагноз врач устанавливает в первый же день по результатам осмотра, изучению истории болезни, жалоб и результатов исследований. Профессионализм врачей Ихилов позволяет безошибочно определять болезнь, так что последующая диагностика подтверждает их выводы.
День второй:
В этот день пациент проходит назначенные исследования. Для диагностики неходжкинской лимфомы могут понадобиться такие исследования:
- анализы крови;
- рентгенографию грудной клетки
- ПЭТ КТ;
- МРТ;
- проточная цитометрия;
- люмбальная или спинальная пункция и другие.
Точную стоимость диагностики неходжкинской лимфомы в Израиле вы можете узнать, заполнив анкету на сайте Ихилов.
День третий:
Уже на третий день лечащий профессор проводит консультацию по окончательному определению диагноза. Обычно онколог приглашает врачей-специалистов в других областях, чье мнение необходимо для разработки эффективной схемы лечения. По результатам проведенных накануне анализов врачи устанавливают диагноз. Затем они определяют план лечения. Пациент всегда присутствует на консилиуме, получает ответы на все интересующие его вопросы, необходимые разъяснения врачей. Уже на следующий день начинается лечение.
Список процедур необходимых для диагностики
Сколько стоят медицинские услуги в Ихилов
Мощная государственная поддержка медицинской отрасли, благотворительная помощь частным клиникам делают стоимость медицинских услуг в Израиле дешевле больше, чем на треть, чем в развитых странах с таким же высоким уровнем медицины. Поэтому поток иностранных пациентов в Израиль увеличивается ежегодно. В клинике Ихилов программы диагностики и лечения выгоднее, чем других клиниках страны благодаря оптимальности и сбалансированности, выработанных за два десятилетия работы. Оплата вносится частями по мере оказания медицинских услуг без предоплаты и посредников.
Преимущества
Безупречная репутация старейшей клиники в Израиле создана благодаря профессионализму врачей клиники. Их имена всемирно известны, статистика положительных результатов исцеления от тяжелых форм рака сделала израильскую медицину легендой. Самое современное высокотехнологическое медицинское оборудование в Израиле помогает врачам Ихилов справляться с опухолями в труднодоступных местах, которые считаются неоперабельными в других странах. В Ихилов пациент получает доступ до всех достижений науки в области лечения рака. Потому что врачи Ихилов первыми внедряют новые методы лечения, вводят в практику инновационные препараты, прошедшие клинические испытания. Поэтому в клинике Ихилов самое эффективное и современное лечение рака.



